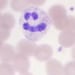

Featured items
All items
Reviews
-

-

-

-

Sara on Mar 28, 2026
5 out of 5 starsIt looks great! I have a small wrist and got a 6.5 inch and it fits perfectly
-

-

Joanne on Feb 16, 2026
5 out of 5 starsLove this item works well with my other bracelets. Thank you
-
Beth on Jan 27, 2026
5 out of 5 starsThis anklet is so cute and an exact match for the necklace that I’ve had for years. I love it! Will be getting the earrings soon to complete the set 🙌🏼 Mike was also very helpful with a shipping question I had.
-

-

Emily on Apr 20, 2026
5 out of 5 starsSuper, super cute! Fits my wrist perfectly and is so shiny. Both bracelets are from Michael’s and they stack so nicely together. Thank you!
About MichaelsCapeCod
Shop policies
Accepted payment methods
Returns & exchanges
Looking for more? Find it on Etsy












































